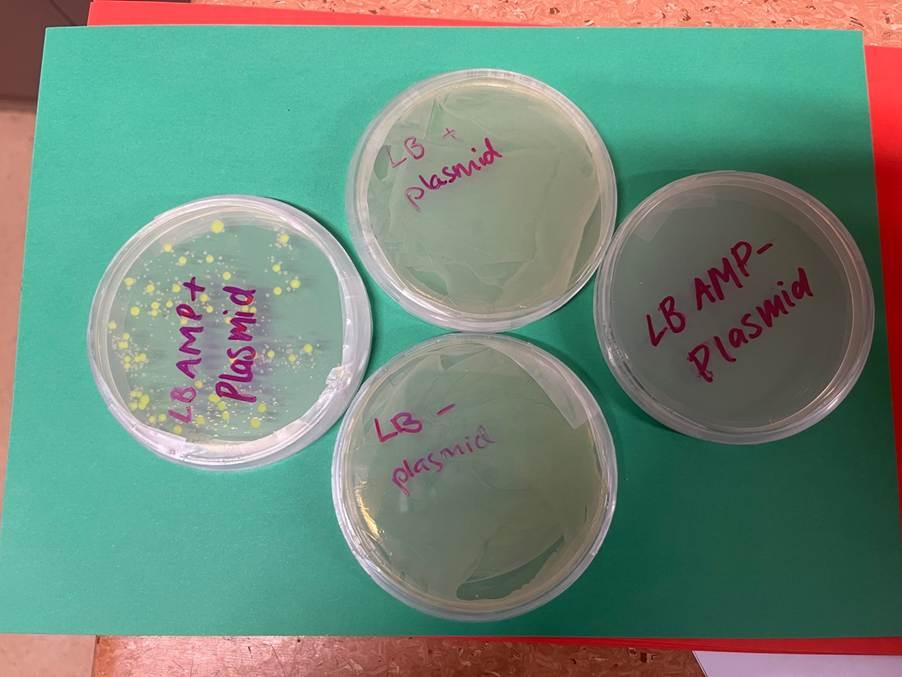
Gallery Image
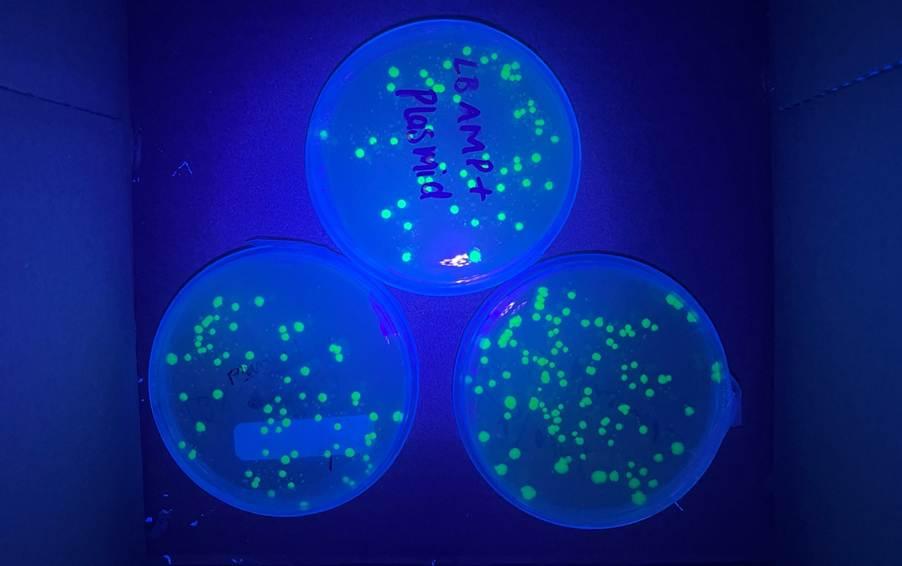
Gallery Image

Around the College

Our Year 10 Live Long Life Long PE class enjoyed a visit to DF Fitness in Leongatha today. Led by instructor Ange, students were challenged in a high-energy spin class before continuing their workout in the gym. It was a fantastic opportunity for students to engage with fitness in our local community, and we thank DF Fitness for their support.
Lighting Up Biology: Students Make Bacteria Glow
Our Year 12 Biology students recently stepped into the world of biotechnology, carrying out a hands-on experiment using bacteria and a bioluminescent gene from jellyfish.
As part of their studies on DNA manipulation, students explored the processes of recombination and transformation. These are two key techniques used in modern genetic engineering. In this practical, students were provided with a recombinant plasmid encoding a fluorescent protein. Their task was to introduce this plasmid into bacterial cells through the process of transformation.
Using a process called heat shock, students encouraged the bacteria to take up the new DNA. They then plated the bacteria onto agar containing an antibiotic, allowing only those cells that had successfully incorporated the plasmid to grow. This selection process is a critical step in biotechnology, helping scientists identify which cells have been successfully transformed.
After incubation, the results were both exciting and visually striking. When placed under ultraviolet (UV) light, many of the bacterial colonies glowed bright green. This was clear evidence that the bacteria had not only taken up the plasmid, but were also expressing the new gene.
This experiment provided students with a valuable insight into how scientists use genetic modification in real-world contexts, such as producing medicines, improving crops, and advancing medical research. It also gave students the opportunity to develop key laboratory skills, including aseptic technique, precision, and careful observation.
Beyond the science, students engaged in thoughtful discussions about the ethical considerations of genetic modification, considering both its benefits and potential concerns.
It was fantastic to see such great curiosity in the lab, with many students fascinated by the results. While others were equally amazed (and slightly horrified!) by just how much bacteria had grown on some of the plates.
We look forward to continuing to explore the amazing world of biology throughout the year!
Our Year 7 students have cooked delicious Taco Boats as part of their Food Technology class!
Humanities Update
It has been a busy and engaging period across Humanities, with students exploring a wide range of historical, economic and cultural topics.
Year 7A students are currently undertaking an assessment on Mungo Man and Mungo Lady, who lived approximately 40,000–42,000 years ago. These significant discoveries at Lake Mungo have reshaped our understanding of Australia’s past, providing some of the earliest evidence of human life, ritual burial practices and continuous Aboriginal culture . Students are developing a deeper appreciation of the rich and enduring history of Australia’s First Peoples—an amazing area of learning.
In Year 11 Economics, students have commenced Area of Study 2 in Unit 1, focusing on how markets operate. They are investigating different market structures, including perfect competition, monopolistic competition, oligopoly, duopoly and monopoly, and applying these concepts to real-world examples within the Australian economy.
Year 12 Economics students are completing Area of Study 1 in Unit 3. Their focus has been on how scarce resources are allocated through the price mechanism, and how price signals influence the behaviour of buyers and sellers. Students will undertake a practice SAC next week as they prepare for SAC 2.
Year 10 History students are examining the end of the Second World War, including the Allied landing in Normandy, the atomic bombings of Hiroshima and Nagasaki, and the Holocaust, alongside the rise of anti-Semitism in Europe. They will soon begin preparing for their topic assessment, which involves analysing primary sources from this significant period in history.
Year 12 Business Management students are finalising their second Area of Study on Human Resource Management and are preparing for their upcoming SAC in the first week back after the Easter break.
Year 9 students have been exploring the First World War. Many have been tracing the journeys of their own ancestors through the Western Front and other battlefields, while others have undertaken detailed research into specific battles and how they are commemorated today.
Year 8 Humanities students have completed their unit on Shogunate Japan and are looking ahead to their next area of study in Civics and Citizenship next term.
Overall, it has been a productive and enriching term across Humanities, with students demonstrating curiosity, critical thinking and a growing understanding of the world around them.